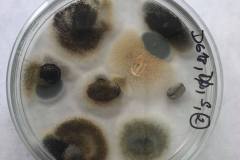
240530050_224459502985936_2274526304622947679_n

Oddelenie biológie na Dni otvorených dverí (DOD) 2024
no images were found
Workshopy pre stredné školy na Oddelení biológie
Oddelenie biológie na DOD 2018
Klub VšeVed – ako sme začali a čo všetko sme spolu zažili
Na labákoch
V teréne a v praxi
Na cestách a výletoch
no images were found
Konferencia Biologické a medicínske vedy, Niğde, Turecko, 2018
Erasmus – zahraničná stáž, Polytechnická univerzita vo Valencii, Španielsko, 2018
Grilovačky, Haluškovanie
Oddelenie biológie na športovom dni 2018
Konferencia Aplikované prírodné vedy (ANS) 2019
no images were found